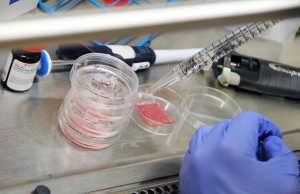

Etiket: yara izi
Yara İzi Bırakmayan Şaşırtıcı Ameliyat, Yaraların İçine Canlı Bir Deri Basıyor
Yara İzi Bırakmayan Şaşırtıcı Ameliyat, Yaraların İçine Canlı Bir Deri Basıyor
Çığır Açan İnsan Benzeri Biyobaskılı Cilt, Yaraları Daha İyi, Daha Hızlı...
Bilim insanları ilk kez altı temel cilt hücresi tipini özel hidrojellerle birleştirerek kalın, çok katmanlı bir cilt 'baskı' yaptı. Bu cilt, nakledildiğinde yaraları daha hızlı ve daha az yara iziyle iyileştirmek için çevredeki dokuyla başarılı bir şekilde bütünleşti.